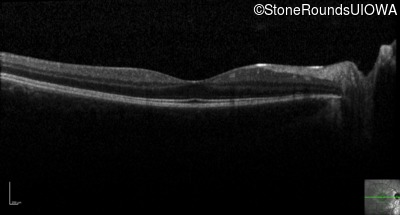
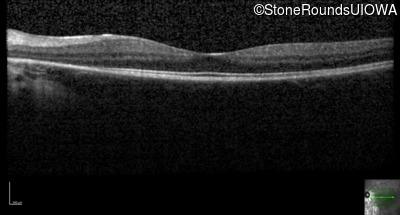
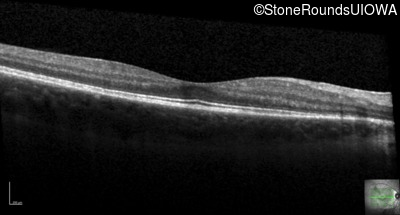
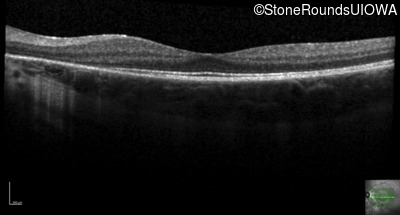
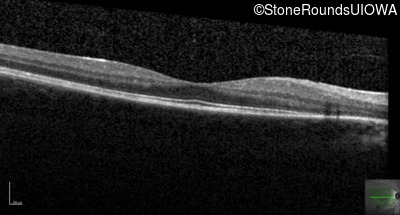
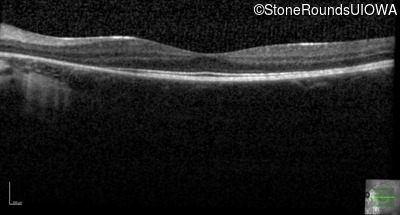
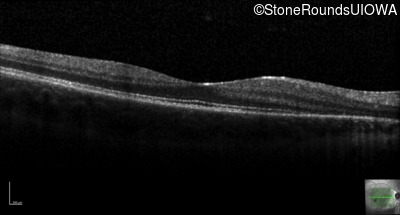

Case
SR1104
Student Mode
Congenital Stationary Night Blindness (IA2f)
Female
Female
Hidden
SR1104
Student Mode
Congenital Stationary Night Blindness (IA2f)
Female
Female
History
This fourteen year old female has had poor vision in dim light since at least age 6.
| Age at visit: 18 years |
| Age at visit: 18 years (Visit 2) |
| Age at visit: 19 years |
Diagnosis & molecular findings
| Disease | Gene | Allele 1 variant(s) | Allele 2 variant(s) | Inheritance mode |
|---|---|---|---|---|
| Congenital Stationary Night Blindness | SLC24A1 | Glu801 del4gAAGGinsTT | Asn893 del1aaT | AR |
Gene:
Allele 1:
Glu801 del4gAAGGinsTT
Allele 2:
Asn893 del1aaT
Inheritance:
AR